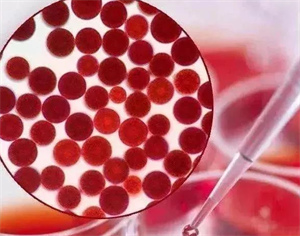

熱線:029-84508548 18189178851
郵箱:herbext-s@undersun.com.cn
地址 : 陜(shan)西省(sheng)咸陽市武功縣(xian)工業(ye)園(yuan)區(qu)奧凱路
產品中心
聯系人:石經理
聯系電話:029-84508548 18189178851
聯系地址:陜西省咸陽市武功縣工業園區奧凱路
【產品名稱】:雨生紅球(qiu)藻
【提取來源】:紅(hong)球藻(zao)
【理化性狀】:紅色粉末
【含量規格】:1%-10%
【檢測方法】:HPLC
【有效成分】:蝦(xia)青素
Related information